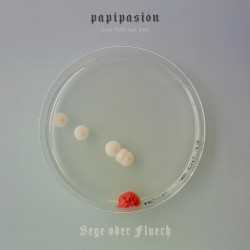
SEGE ODER FLUECH

papipasión
Type
Person
Location
🇨🇭 Switzerland
Albums2
- 2023
- 2022
EPs2
- 2023
- 2022
Singles16
- 2023
- 2023
- 2023
- STARSpapipasión & Kylo Dream2023
- T‐SHIRT (Reworn)papipasión & Lil Bruzy2022
- GLIZZY (Reloaded)papipasión & Jule X2022
- 2022
- 2022
- 2022
- FarbeZvZ feat. papipasión2022
- 2022
- 2022
- DefenseZvZ feat. papipasión2022
- 2021
- SEGE ODER FLUECHpapipasión feat. ZvZ2021
- 2020